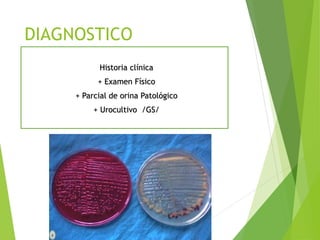
DIAGNOSTICO
Historia clínica
+ Examen Físico
+ Parcial de orina Patológico
+ Urocultivo /GS/

Este documento trata sobre las infecciones del tracto urinario en pediatría. Define las infecciones del tracto urinario, explica su localización y evolución posible, factores de riesgo, etiología, manifestaciones clínicas, diagnóstico, tratamiento y profilaxis. Aborda temas como cistitis, pielonefritis aguda y bacteriuria asintomática.